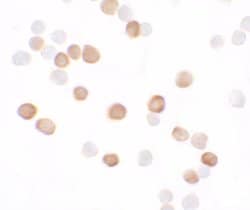
Invitrogen KREMEN2 Polyclonal Antibody 100 &mu;g; Unconjugated:Antibodies,

missing translation for 'onlineSavingsMsg'
Learn More
Learn More
Invitrogen™ KREMEN2 Polyclonal Antibody
Rabbit Polyclonal Antibody
Brand: Invitrogen™ PA534525
This item is not returnable.
View return policy
Description
A suggested positive control is Hela cell lysate. PA5-34525 can be used with blocking peptide PEP-1568.
Kremen (Kringle containing protein marking the eye and the nose) proteins are type I transmembrane proteins that contain extracellular kringle, WSC and CUB domains and an intracellular region without any conserved motifs. Kremens bind a subset of the secreted Dickkopf proteins (Dkk 1, 2, and 4) with high affinity to modulate the canonical Wnt signaling pathway that is transduced by the ternary receptor complex composed of Wnt, Frizzled, and the LDL receptor related protein 5/6 (LRP5/6) co-receptor. Recent experiments have shown that KREMEN2 is a regulator of bone remodeling and raise the possibility that antagonizing KREMEN2 might prove beneficial in patients with bone loss disorders.
Specifications
| KREMEN2 | |
| Polyclonal | |
| Unconjugated | |
| KREMEN2 | |
| 2900054E04Rik; Dickkopf receptor 2; kremen protein 2; KREMEN2; kringle containing transmembrane protein 2; kringle domain-containing transmembrane protein 2; Kringle-containing protein marking the eye and the nose; Krm2 | |
| Rabbit | |
| Antigen affinity chromatography | |
| RUO | |
| 73016, 79412 | |
| Maintain refrigerated at 2-8°C for up to 3 months. For long term storage store at -20°C | |
| Liquid |
| Western Blot, Immunocytochemistry | |
| 1 mg/mL | |
| PBS with 0.02% sodium azide | |
| Q8K1S7, Q8NCW0 | |
| KREMEN2 | |
| A peptide corresponding to 14 amino acids near the carboxy terminus of human KREMEN2. The immunogen is located within amino acids 390-440 of KREMEN2. | |
| 100 μg | |
| Primary | |
| Human, Mouse | |
| Antibody | |
| IgG |
Product Content Correction
Your input is important to us. Please complete this form to provide feedback related to the content on this product.
Product Title
Spot an opportunity for improvement?Share a Content Correction